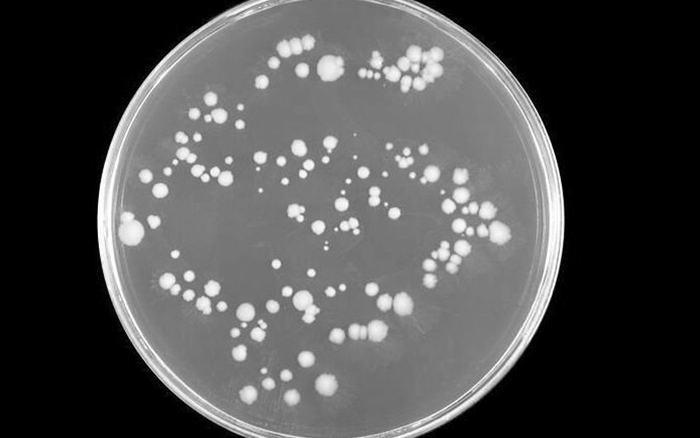

Чего достигла советская космонавтика в период своего бесспорного лидерства
Тема космонавтики никогда не потеряет актуальности, так как человечество рвалось к знаниям о звездах еще с самой глубокой древности. В будущем темп освоения космического пространства будет только нарастать по мере новых открытий в сфере ракетостроения, металлов и сплавов, микроэлектроники и медицины. И дело, даже, не в том, что человечеству нужно приготовиться к повальной колонизации близлежащих планет или звездных систем и оставлению Земли.
Дело в том, что космос нужно осваивать, потому что нужно искать новые энергоресурсы. Вот и все. А то, что в будущем, будет необходимо покинуть Землю, когда Солнце израсходует свой запас топлива - это такая дальняя перспектива, что пока что о ней речи и быть не может.
Нас же волнует следующее. Какое место в освоении космического пространства займет Россия. Многие люди имеют плохое мнение о современной российской космонавтике, утверждая, что она находится в упадке, а дело в ней - не доходит дальше обещаний о завтрашнем зените и предстоящих победах. Многие проекты были закрыты или получив финансирование - успешно нереализованы. Основной вопрос: "Где деньги?" - остается открытым.
Но если вглядеться, то можно заметить, что последние лет 5 в нашей космонавтике пошли серьезные подвижки и реальные дела. Космодром "Восточный" достраивается ударными темпами, налажено строительство новой тяжелой ракеты "Ангара", наметилось строительство отечественной орбитальной станции, вплотную подошли к испытаниям новейшего космического корабля "Орел", с этого года начинает свое действие лунная программа, анонсировали разработку собственного многоразового космического корабля.
Все это хорошо, главное - результат, который мы с нетерпением будем ждать в этом десятилетии. Главным, на кого нужно равняться, по мнению обывателей - это Китай. Смотря на темпы реализации его космической программы - наворачивается простое человеческое уныние и вопрос: "Неужели, мы не можем развивать нашу космонавтику такими же ударными темпами".
Но, на сегодня, давайте я вам напомню, что было уже в истории нашей страны такое. Советский Союз всего 40-60 лет назад, такими же быстрыми темпами сделал множество открытий в космосе, поставил мировые рекорды и отправил огромное количество аппаратов к космическим телам Солнечной системы.
К таким рекордам можно отнести: отправку первого спутника на орбиту Земли в 1957 году, отправку первого космонавта в космос в 1961 году. Первым человеком, побывавшим в космосе - стал Юрий Гагарин. Первым космонавтом, вышедшим в открытый космос - стал Алексей Леонов. Кроме того, наша космонавтика не отстала и в изучении Луны. Конечно, людей мы туда отправить не успели. Зато, хорошо отработали наши автоматические станции.
Аппараты серии "Луна" первыми в мире сумели произвести облет Луны и фотографирование обратной стороны естественного спутника Земли. Кроме того, станция "Луна-16", сумела в автоматическом режиме доставить образцы лунного реголита с поверхности Луны, благодаря автоматическому возвращаемому аппарату. Это была первая в истории доставка образцов пород с другого космического тела. Еще нельзя забывать о двух советских луноходах - ставшими первыми в мире автоматическими планетоходами.
Отдельно, нужно отметить изучение советскими автоматическими аппаратами планеты Венера, которую ведь не зря называют "Русской планетой". Основные открытия и единственные в истории высадки автоматических аппаратов на поверхность Венеры, с последующим фотографированием и анализом происходящего на поверхности - сделаны именно нашими учеными, благодаря серии аппаратов "Венера". Вообще, в принципе, аппараты серии "Венера" - стали первыми в истории аппаратами, созданным руками человека и достигшими внеземной поверхности. Произошло это в 1970 году.
Аппараты "Марс-2" и "Марс-3" - стали первыми аппаратами, которые были доставлены на поверхность Красной планеты. Один аппарат разбился, второй отправил некоторые данные на Землю, но через 20 секунд - его работа была прервана пыльной бурей. Но то были спускаемые модули. Аппараты, оставшиеся на орбите Марса - продолжили картографирование Марса и оставили заметный вклад в науку в этой области деятельности. Произошло это в 1971 году.
Советский Союз стал первым и в строительстве первых орбитальных станций. Такой стала станция "Салют-1", запущенная в 1971 году. Всего было запущено 7 станций типа "Салют" и "Космос-557". Но и на этом Советский Союз не остановился и была построена первая в мире многомодульная космическая станция. Первый ее модуль был доставлен на орбиту в 1986 году. В 2001 году станция была затоплена в Тихом океане, по официальной версии в связи с отработкой ее ресурса.
Отдельно, нужно отметить создание советской многоразовой транспортной космической системы (МТКС) "Энергия-Буран". Это был настоящий зенит отечественной космонавтики, когда созданный корабль, оказался на порядок лучше своего прототипа - американского "Спейс шаттла". А ракета "Энергия" - была ракетой, которая могла выполнять всевозможные задачи. Это и доставку модулей новой орбитальной станции. Доставку модулей космического корабля, предназначенного для полета на Луну, Венеру или Марс, сборка которого осуществлялась бы на орбите Земли, что удешевило бы его стоимость. Распад Советского Союза поставил точку в этом проекте и вряд ли такой проект нужен будущему космонавтики в принципе.
Если Вам понравилась статья - поставьте лайк. Будем рады вашей подписке на нашу страницу в Пикабу и сообщество в ВК, а также сообщество в Пикабу "Все о космосе".